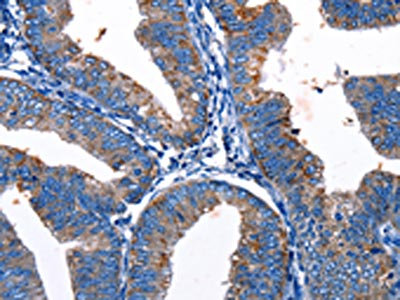

Gjc3 Antibody
-
中文名稱:Gjc3兔多克隆抗體
-
貨號:CSB-PA448173
-
規格:¥1100
-
圖片:
-
The image on the left is immunohistochemistry of paraffin-embedded Human cervical cancer tissue using CSB-PA448173(Gjc3 Antibody) at dilution 1/10, on the right is treated with synthetic peptide. (Original magnification: ×200)
-
The image on the left is immunohistochemistry of paraffin-embedded Human colon cancer tissue using CSB-PA448173(Gjc3 Antibody) at dilution 1/10, on the right is treated with synthetic peptide. (Original magnification: ×200)
-
-
其他:
產品詳情
-
Uniprot No.:
-
基因名:Gjc3
-
別名:Gjc3; Cx29; Gje1; Gap junction gamma-3 protein; Connexin-29; Gap junction epsilon-1 protein
-
宿主:Rabbit
-
反應種屬:Human,Mouse
-
免疫原:Synthetic peptide of Mouse Gjc3
-
免疫原種屬:Mus musculus (Mouse)
-
標記方式:Non-conjugated
-
抗體亞型:IgG
-
純化方式:Antigen affinity purification
-
濃度:It differs from different batches. Please contact us to confirm it.
-
保存緩沖液:-20°C, pH7.4 PBS, 0.05% NaN3, 40% Glycerol
-
產品提供形式:Liquid
-
應用范圍:ELISA,IHC
-
推薦稀釋比:
Application Recommended Dilution ELISA 1:1000-1:2000 IHC 1:10-1:50 -
Protocols:
-
儲存條件:Upon receipt, store at -20°C or -80°C. Avoid repeated freeze.
-
貨期:Basically, we can dispatch the products out in 1-3 working days after receiving your orders. Delivery time maybe differs from different purchasing way or location, please kindly consult your local distributors for specific delivery time.
-
用途:For Research Use Only. Not for use in diagnostic or therapeutic procedures.
相關產品
靶點詳情
-
功能:One gap junction consists of a cluster of closely packed pairs of transmembrane channels, the connexons, through which materials of low MW diffuse from one cell to a neighboring cell.
-
基因功能參考文獻:
- Induction of Cxs 29 and 32 in the injury border suggests that altered Cx expression may contribute to the propagation of injury-related and/or regeneration signals after acute brain injury. PMID: 20926974
- Cx29 is a second connexin expressed in Schwann cells of sciatic nerve. PMID: 12372015
- Comparative mapping of Y1 and Y5 receptor subtypes within cell bodies and nerve fibers in the brain. Together with physiological and electrophysiological studies, provides better understanding of NPY neural circuitries. PMID: 12900929
- Cx29 is localized to the inner membrane of small myelin sheaths PMID: 15293232
- Our data first provide a comprehensive and detailed pattern of Cx29 gene expression in the mouse and rat cochlea. PMID: 16236250
- Thus, in contrast to connexin32 and connexin47, which are also expressed in myelinating cells, Cx29 does not contribute to the function of myelin in adult mice. PMID: 16435366
- Findings demonstrated the requirement of Cx29 for normal cochlear functions and suggest that Cx29 is a new candidate gene for studying the auditory neuropathy. PMID: 16481432
- Cx29 protein expression was absent from neural crest cells but appeared as neural crest cells generated precursors (embryonic day 12) both in vivo and in vitro. This identifies Cx29 as a novel marker for cells of the defined Schwann cell lineage. PMID: 17024657
- Homomeric interactions of Cx29 and Cx32 require other domains: the N-terminus, transmembrane domains, and extracellular loops. Substituting the intracellular loop and/or tail of Cx32 with those of Cx29 prevents Cx32 from forming functional gap junctions. PMID: 17972320
- Cx23 seems to share functional properties with pannexin (hemi) channels rather than gap junction channels of other connexins. PMID: 18849090
顯示更多
收起更多
-
亞細胞定位:Cell membrane; Multi-pass membrane protein. Cell junction, gap junction.
-
蛋白家族:Connexin family, Gamma-type subfamily
-
組織特異性:CNS specific. Expression is restricted to brain, spinal cord, and sciatic nerve.
-
數據庫鏈接:
Most popular with customers
-
YWHAB Recombinant Monoclonal Antibody
Applications: ELISA, WB, IHC, IF, FC
Species Reactivity: Human, Mouse, Rat
-
Phospho-YAP1 (S127) Recombinant Monoclonal Antibody
Applications: ELISA, WB, IHC
Species Reactivity: Human
-
-
-
-
-
-